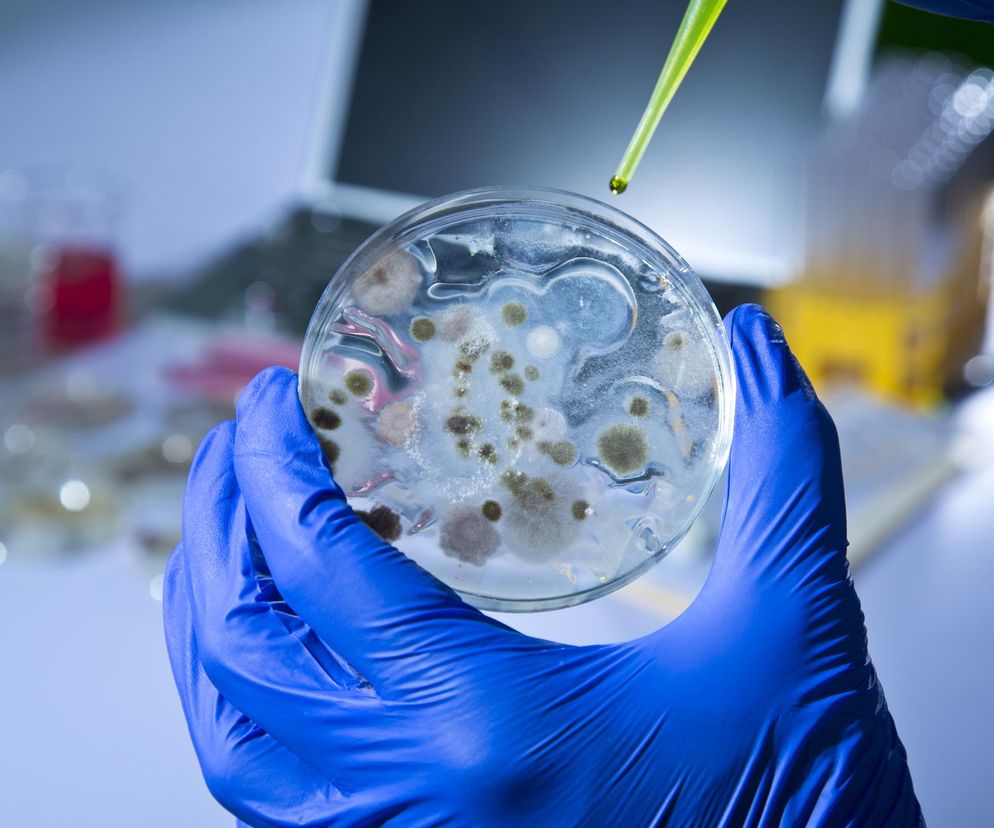
Wąglik w Chorwacji. Opieką medyczną objęto kilkadziesiąt osób. Trwają szczepienia (zdjęcie ilustracyjne)

Ministerstwo rolnictwa Chorwacji ogłosiło w czwartek nowe środki w zakresie kontroli i zwalczania wąglika, którego bakterie wykryto w ostatni weekend u zwierząt hodowlanych. Chorwackie władze ogłosiły wcześniej kilka gmin kraju tzw. rejonami wąglikowymi.
Sprawdź, jakie obostrzenia obowiązują, szczególnie gdy wybierasz się na urlop do Chorwacji.
Chorwacja - obostrzenia związane z wąglikiem
Ministerstwo zobowiązało hodowców do natychmiastowego skontaktowania się z weterynarzem w przypadku zaobserwowania jakichkolwiek symptomów wąglika. Gdy zwierzę padnie, konieczne jest zabezpieczenie go folią, spryskanie specjalnym środkiem i odizolowanie ciała od pozostałych zwierząt (w tym owadów i ptaków) oraz ludzi.
Na terenach, na których wykryto obecność wąglika, zabroniono:
- polowań,
- prac rolnych,
- wypasu zwierząt.
Chorwacja - gdzie i do kiedy obowiązują zakazy
Zakaz na danym obszarze będzie obowiązywać przez 21 dni od daty zaszczepienia ostatniego zwierzęcia lub ostatniego potwierdzonego przypadku choroby. Kampania szczepień przeciwko wąglikowi trwa w Chorwacji od kilku dni.
W poniedziałek 21 lipca władze kraju wyznaczyły kilka tzw. rejonów wąglikowych, do których włączono 10 gmin w żupaniach splicko-dalmatyńskiej i szybenicko-knińskiej. Na obszarach tych obowiązuje zakaz przemieszczania zwierząt, uboju, sprzedaży mięsa i koszenia traw.
Te szczepienia trzeba powtarzać
Wąglik w Chorwacji - czy jest zagrożenie dla ludzi?
Wąglik (anthrax) jest ostrą chorobą odzwierzęcą, wywołaną przez bakterię - laseczkę wąglika. Gdy wąglik zaatakuje układ oddechowy człowieka, zakażenie ma przebieg gwałtowny i najczęściej kończy się śmiercią. Kolejną złą wiadomością jest to, że choroba jest bardzo trudna do zdiagnozowania.
Po wykryciu w weekend wąglika u zwierząt opieką medyczną objęto w Chorwacji kilkadziesiąt osób, które mogły zarazić się chorobą. Premier Andrej Plenković ogłosił w czwartek, że obecnie nie ma potwierdzonych przypadków jej występowania u ludzi.
Szef chorwackiego rządu zapowiedział też programy pomocowe dla rolników.